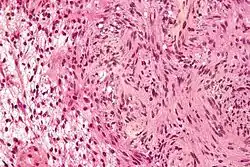

شفاني
شفاني أو ورم شوان(بالإنجليزية: Schwannoma).ويعرف أيضا بعدة أسماء هي:،" "ورم المحاوير،""ورم غمد الليف العصبي"، "شوان ورم الخلايا" ."[1] هو تكاثر خلوي سليم(حميد) ينشأ من غلاف الخلية العصبية ويتواجد غالباً في النسج الرخوة في منطقة الرأس و العنق.وهذا التكاثر الخلوي أو الورم الحميد في العصب، ينشأ من في خلايا شفان، وهي الخلايا التي تنتج الغلالة النخاعينية التي تغطي الأعصاب الطرفية وتسمى الأورام الناشئة من خلايا شفان الشفانوما. وهذه الأورام المتجانسة تتكون فقط من خلايا شفان. وتبقى الخلايا الورمية خارج العصب دائما، ولكن الورم قد يدفع العصب جانباً، أو ضد بناء عظمي مما قد يتسبب في ضرر العصب. والأورام تنمو ببطئ، وهي غالباً أورام حميدة. ولكن هناك إمكانية لتحولها إلى خبيثة وتسمى عندها وتنشأ الشفانومات من خلل وراثي يسمى الورام الليفي العصبي. سميت هذه الأورام نسبة إلى الطبيب الألماني شفان فريدريش ثيودور 1810-1882.
| شفاني | |
|---|---|
![]() صورة مجهرية من ورم شفاني تظهر كل من منطقة أنتوني الخلوية (وسط ويمين الصورة) وجزئية منطقة B أنتوني فضفاضة (الحافة اليسرى من الصورة)
DiseasesDB
= 33713 صورة مجهرية من ورم شفاني تظهر كل من منطقة أنتوني الخلوية (وسط ويمين الصورة) وجزئية منطقة B أنتوني فضفاضة (الحافة اليسرى من الصورة)
DiseasesDB= 33713 | |
| معلومات عامة | |
| الاختصاص | علم الأورام |
| من أنواع | ورم عصبي |
الأعراض
تنمو الأورام ببطئ بدون ألم، وتكون متحركة تحت سطح الغلالة النخاعينية، ويمكن أن تحدث في جميع الأعمار ولكنها تكون أكثر شيوعا عند كبار السن، وقد توجد بشكل نادر في اللسان مما قد يؤدي إلى كبر اللسان، لكنه قد ينشأ في أي بقعة في الفم، كما قد تحدث في الأذن وفي الساق في الضفيرة العجزية والضفيرة العضدية.
العلاج
تعالج أمراض الشفاني غالبا عن طريق الجراحة، حيث يتم استئصال الورم، ويمكن حاليا استخدام الليزر في عملية الاستئصال، وقد يعود الورم بعد استئصاله. ويمكن استئصاله مرة أخرى.
صور إضافية

.JPG.webp)
Subcutaneous schwannoma_Antoni_B.jpg.webp)
_Antoni_B.jpg.webp)
_S-100_immunostain.jpg.webp)
انظر أيضا
- ورم ليفي عصبي(بالإنجليزية: Neurofibroma)
المراجع
- Rapini, Ronald P.; Bolognia, Jean L.; Jorizzo, Joseph L. (2007). Dermatology: 2-Volume Set. St. Louis: Mosby. ISBN 1-4160-2999-0. الوسيط
|CitationClass=تم تجاهله (مساعدة)صيانة CS1: أسماء متعددة: قائمة المؤلفون (link)
وصلات اضافية
http://www.cancerresearchuk.org/cancer-help/about-cancer/cancer-questions/what-is-schwannoma
http://rarediseases.info.nih.gov/gard/4767/schwannoma/resources/1
- بوابة طب